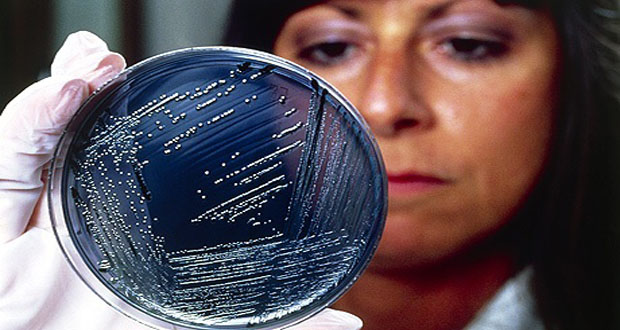

لندن-سانا
نجح علماء بريطانيون ويابانيون في إعادة ضبط الخلايا الجذعية البشرية وإعادتها إلى وضعها المبكر الأصلي ليفتحوا بذلك عالماً جديداً من الأبحاث حول بداية تطور البشرية والتي قد تستخدم لإنقاذ الحياة في مجالات الطب.
ونقلت رويترز عن العلماء قولهم إنهم تمكنوا من إعادة ضبط الخلايا الجذعية متعددة الإمكانات وإرجاعها إلى حالتها الأصلية حتى تضاهي خلايا جنين عمره من سبعة أيام إلى عشرة قبل زرعها في الرحم.
وأعرب العلماء عن أملهم بأن يتمكنوا عبر دراسة هذه الخلايا من معرفة المزيد عن مراحل تطور الأجنة وكيف يمكن أن تحيد عن الوضع الصحيح ما يتسبب في حدوث الإجهاض والاضطرابات الأخرى الخاصة بنمو الجنين.
وأكد العلماء أنه يمكن الإستعانة بهذه الخلايا في إنتاج الأنسجة ما يتيح لعلم الخلايا الجذعية استنباط سبل جديدة لعلاج حالات ميئوس من شفائها حالياً منها أمراض القلب والعيون والشلل الرعاش والسكتة الدماغية.
يذكر أنه بمقدور الخلايا الجذعية البشرية متعددة الإمكانات أن تتخصص ويمكن إنتاجها بالفعل داخل المعامل إما من خلال استخلاصها من مراحل جنينية مبكرة وإما من خلايا بالغة أمكن التأثير عليها أو إعادة برمجتها لتصبح خلايا في مراحلها المبكرة.
S A N A الوكالة العربية السورية للأنباء